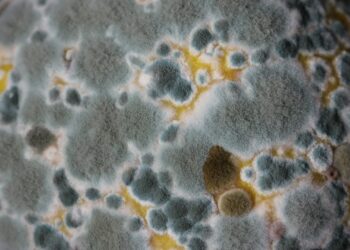
Marca gigante vai pagar R$ 14,99 de indenização por comida mofada

Copyright Tribuna de Minas.
Dinheiro
Falsos atendentes bancários roubam dados em ligação telefônica
Embora os bancos estejam constantemente aprimorando suas medidas de segurança digital, visando proteger os clientes e acompanhar os avanços tecnológicos,...
Leia maisDetailsConta de luz dispara com bandeira vermelha e exige economia urgente
Na última sexta-feira (31), a Agência Nacional de Energia Elétrica (Aneel) fez um alerta preocupante sobre a conta de luz....
Leia maisDetailsAtenção, MEIs: Receita do CPF pode se unir ao CNPJ
Por conta da publicação da Resolução CGSN nº 183/2025, trabalhadores do regime de Microempreendedor Individual (MEI) precisam se preparar para...
Leia maisDetailsApps de entrega entram na mira do Cade em disputa acirrada pelo mercado
Com a recente chegada dos aplicativos de delivery 99Food e Keeta ao Brasil, o país se tornou cenário de uma...
Leia maisDetailsTJ obriga plano privado a liberar verba escondida de beneficiários
Beneficiários de um plano VGBL (Vida Gerador de Benefício Livre) de uma operadora de previdência privada precisaram recorrer à Justiça...
Leia maisDetailsQuer receber o teto do INSS? Veja como aumentar o valor da sua aposentadoria
Em janeiro deste ano, os benefícios do Instituto Nacional do Seguro Social (INSS) foram reajustados e, com isso, o teto...
Leia maisDetailsCartões de crédito fáceis para quem tem nome negativado no Serasa
Estar com o nome negativado no Serasa é uma das maiores barreiras enfrentadas por quem precisa de crédito. Ter dívidas...
Leia maisDetailsMarca gigante vai pagar R$ 14,99 de indenização por comida mofada
Uma indenização recente chamou a atenção dos consumidores. Geralmente, alimentos vencidos ou com mofo figuram entre as maiores preocupações das...
Leia maisDetailsPaís quer colocar 12 horas de jornada de trabalho
A jornada de trabalho vem sendo pauta ao redor do mundo. Enquanto discussões sobre a possibilidade de redução de escalas...
Leia maisDetailsBancos só serão liberados para consignado do INSS quando pagarem cobrança indevida
Por conta de fatores como a facilidade de aprovação, taxas de juros mais confortáveis e pagamentos mais dilatados, o empréstimo...
Leia maisDetails